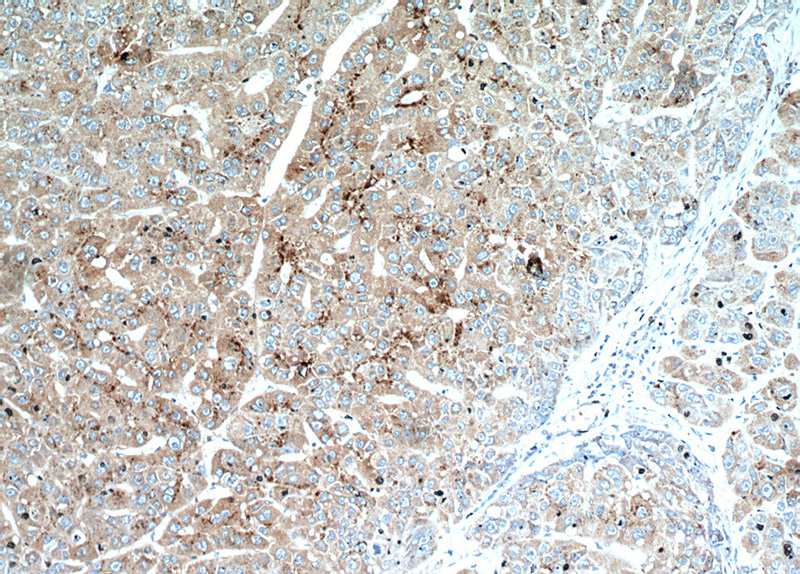
Immunohistochemical of paraffin-embedded human liver cancer using Catalog No:115219(SET antibody) at dilution of 1:100 (under 10x lens)
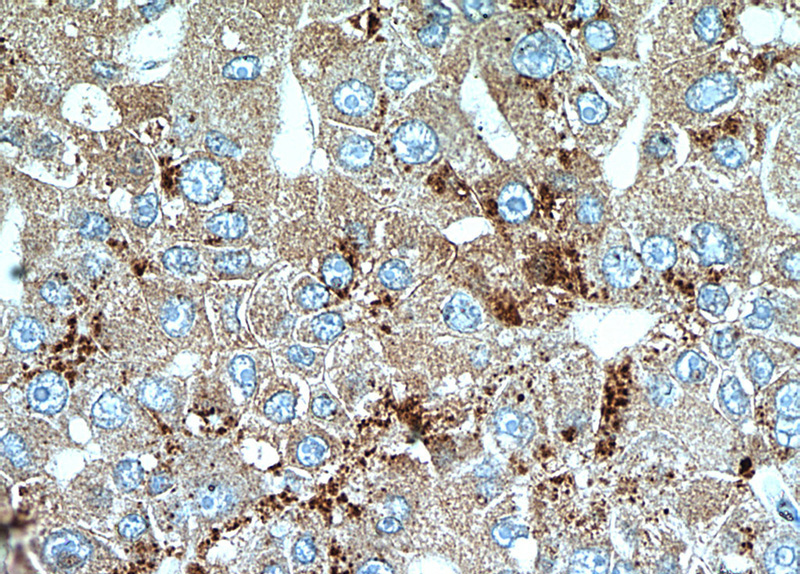
Immunohistochemical of paraffin-embedded human liver cancer using Catalog No:115219(SET antibody) at dilution of 1:100 (under 40x lens)

-
Product Name
SET antibody
- Documents
-
Description
SET Rabbit Polyclonal antibody. Positive IHC detected in human liver cancer tissue, human gliomas tissue, human kidney tissue. Positive WB detected in HeLa cells, HEK-293 cells. Observed molecular weight by Western-blot: 33-37 kDa
-
Tested applications
ELISA, WB, IHC
-
Species reactivity
Human,Mouse,Rat; other species not tested.
-
Alternative names
2PP2A antibody; HLA DR assOCiated protein II antibody; I 2PP2A antibody; I2PP2A antibody; IGAAD antibody; IPP2A2 antibody; PHAPII antibody; Protein SET antibody; SET antibody; SET nuclear oncogene antibody; TAF I antibody; TAF IBETA antibody; Template activating factor I antibody
-
Isotype
Rabbit IgG
-
Preparation
This antibody was obtained by immunization of Peptide (Accession Number: NM_003011). Purification method: Antigen affinity purified.
-
Clonality
Polyclonal
-
Formulation
PBS with 0.02% sodium azide and 50% glycerol pH 7.3.
-
Storage instructions
Store at -20℃. DO NOT ALIQUOT
-
Applications
Recommended Dilution:
WB: 1:500-1:5000
IHC: 1:20-1:200
-
Validations

HeLa cells were subjected to SDS PAGE followed by western blot with Catalog No:115219(SET antibody) at dilution of 1:1000
Immunohistochemical of paraffin-embedded human liver cancer using Catalog No:115219(SET antibody) at dilution of 1:100 (under 10x lens)
Immunohistochemical of paraffin-embedded human liver cancer using Catalog No:115219(SET antibody) at dilution of 1:100 (under 40x lens)
-
Background
SET, also named as IGAAD, I-2PP2A, TAF-I, IGAAD and PHAPII, belongs to the nucleosome assembly protein (NAP) family. It is a multitasking protein which involved in apoptosis, transcription, nucleosome assembly and histone binding. In the course of cytotoxic T-lymphocyte (CTL)-induced apoptosis, GZMA cleaves SET, disrupting its binding to NME1 and releasing NME1 inhibition. The predominant target for inhibition is histone H4. HAT inhibition leads to silencing of HAT-dependent transcription and prevents active demethylation of DNA. Both isoforms stimulate DNA replication of the adenovirus genome complexed with viral core proteins; however, isoform 2 specific activity is higher. This antibody is specific to SET. It can recognize isoform1 and isoform2 of SET.
-
References
- Liu H, Gu Y, Wang H. Overexpression of PP2A inhibitor SET oncoprotein is associated with tumor progression and poor prognosis in human non-small cell lung cancer. Oncotarget. 6(17):14913-25. 2015.
- Yang Y, Huang Q, Lu Y, Li X, Huang S. Reactivating PP2A by FTY720 as a novel therapy for AML with C-KIT tyrosine kinase domain mutation. Journal of cellular biochemistry. 113(4):1314-22. 2012.
- Liu H, Gu Y, Yin J. SET-mediated NDRG1 inhibition is involved in acquisition of epithelial-to-mesenchymal transition phenotype and cisplatin resistance in human lung cancer cell. Cellular signalling. 26(12):2710-20. 2014.
Related Products / Services
Please note: All products are "FOR RESEARCH USE ONLY AND ARE NOT INTENDED FOR DIAGNOSTIC OR THERAPEUTIC USE"
